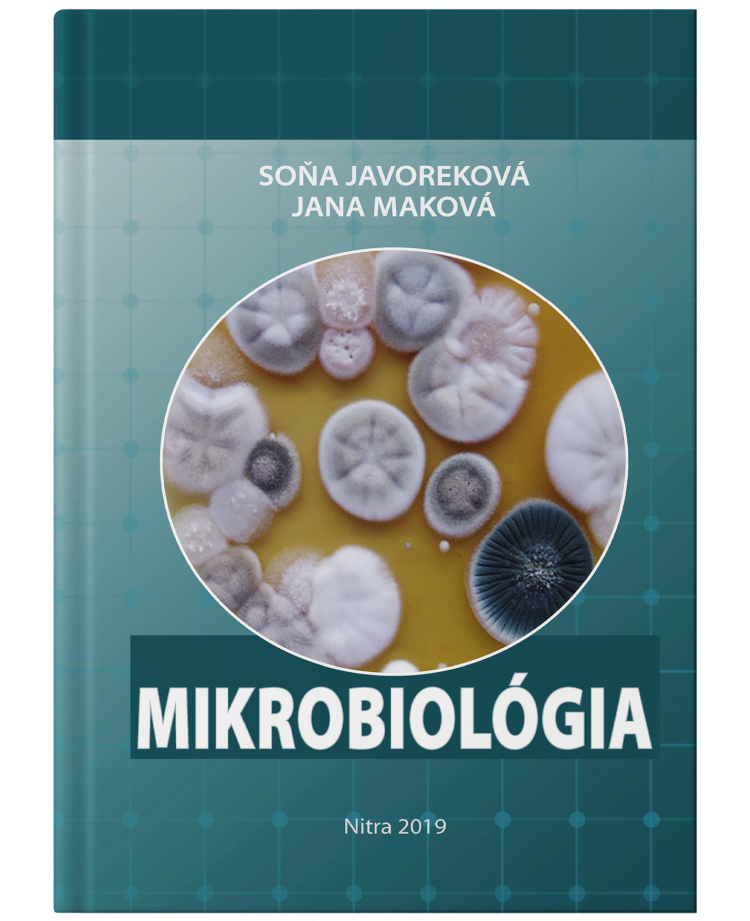
Mikrobiológia

Javoreková Soňa, Maková Jana
Ak potrebujete podrobnejšie informácie o publikácii môžete si stiahnuť jej náhľad v časti Prílohy. Náhľad je dostupný zdarma. Ak sa karta Prílohy nezobrazuje, publikácia nemá dostupný náhľad.
Špecifické referencie